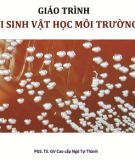
Vi sinh vật học môi trường: PGS. TS. Ngô Tự Thành

Thư viện Môi trường đô thị nông thôn – Tổng hợp kiến thức & Bài tập thực hành
Môi trường đô thị nông thôn (Urban and Rural Environment) là môn học nghiên cứu sự khác biệt và mối liên hệ giữa môi trường tự nhiên – xã hội ở đô thị và nông thôn. Môn học không chỉ giúp sinh viên hiểu về các vấn đề môi trường đặc thù của từng khu vực mà còn cung cấp các công cụ và giải pháp quản lý để phát triển bền vững, cân bằng giữa tăng trưởng kinh tế và bảo vệ môi trường.


![Bài giảng Cấp nước và vệ sinh môi trường nông thôn [chuẩn nhất]](https://cdn.tailieu.vn/images/document/thumbnail/2025/20250522/phongtrongkim2025/135x160/406_bai-giang-cap-nuoc-va-ve-sinh-moi-truong-nong-thon.jpg)



![Bài giảng Sinh thái môi trường TS. Ngô An [FULL]](https://cdn.tailieu.vn/images/document/thumbnail/2021/20211217/caphesuadathemot/135x160/8761639730137.jpg)

![Bài giảng Khí tượng nông nghiệp: Chương 4 [Tóm tắt kiến thức trọng tâm]](https://cdn.tailieu.vn/images/document/thumbnail/2021/20211210/bachkhinhdaluu/135x160/9941639130616.jpg)




![Đề cương học phần Quản lý môi trường đô thị và khu công nghiệp - ĐH Thủy Lợi [Mới nhất]](https://cdn.tailieu.vn/images/document/thumbnail/2021/20210417/lovebychance01/135x160/5321618652020.jpg)